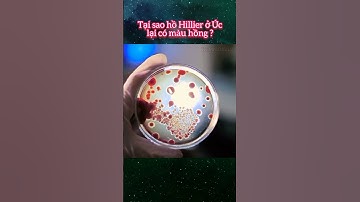
Tại sao hồ Hillier ở Úc lại có màu hồng | Kiến Thức Mỗi Ngày Official #shorts

⬇ DOWNLOAD NOW
Kalau muncul iklan pop-up, tutup lalu klik tombol kembali
Download lagu 3 Sự Thật Thú Vị Mà Chỉ Nước Úc Mới Có #suthatcucnhanh #shorts secara gratis hanya untuk keperluan promosi. Dukung artis favorit kamu dengan membeli musik original di iTunes atau platform resmi lainnya.
 Nước Úc đặc biệt thú vị như thế nào #shorts
Nước Úc đặc biệt thú vị như thế nào #shorts
 Những Sự Thật Thú Vị Về Nước Úc - Australia
Những Sự Thật Thú Vị Về Nước Úc - Australia
 30 Sự Thật Thú Vị CHỈ Có Thể Tồn Tại Ở Nước Úc | 100 Facts Gói Lại Bán Đê #35
30 Sự Thật Thú Vị CHỈ Có Thể Tồn Tại Ở Nước Úc | 100 Facts Gói Lại Bán Đê #35
Tại sao hồ Hillier ở Úc lại có màu hồng | Kiến Thức Mỗi Ngày Official #shorts
Tại sao hồ Hillier ở Úc lại có màu hồng | Kiến Thức Mỗi Ngày Official #shorts
 Sự thật thú vị về nước Úc (p4) #shorts #recycle
Sự thật thú vị về nước Úc (p4) #shorts #recycle
 Những sự thật thú vị về nước Úc - Có thể bạn chưa biết! #shorts #duhoc #duhocuc #duhocaau #aau
Những sự thật thú vị về nước Úc - Có thể bạn chưa biết! #shorts #duhoc #duhocuc #duhocaau #aau
 Quỷ Úc có thật sự đáng sợ 🤔 Dương Phạm #shorts
Quỷ Úc có thật sự đáng sợ 🤔 Dương Phạm #shorts
 Lý do khiến Australia phải loại hàng triệu con chuột túi mỗi năm #Shorts
Lý do khiến Australia phải loại hàng triệu con chuột túi mỗi năm #Shorts